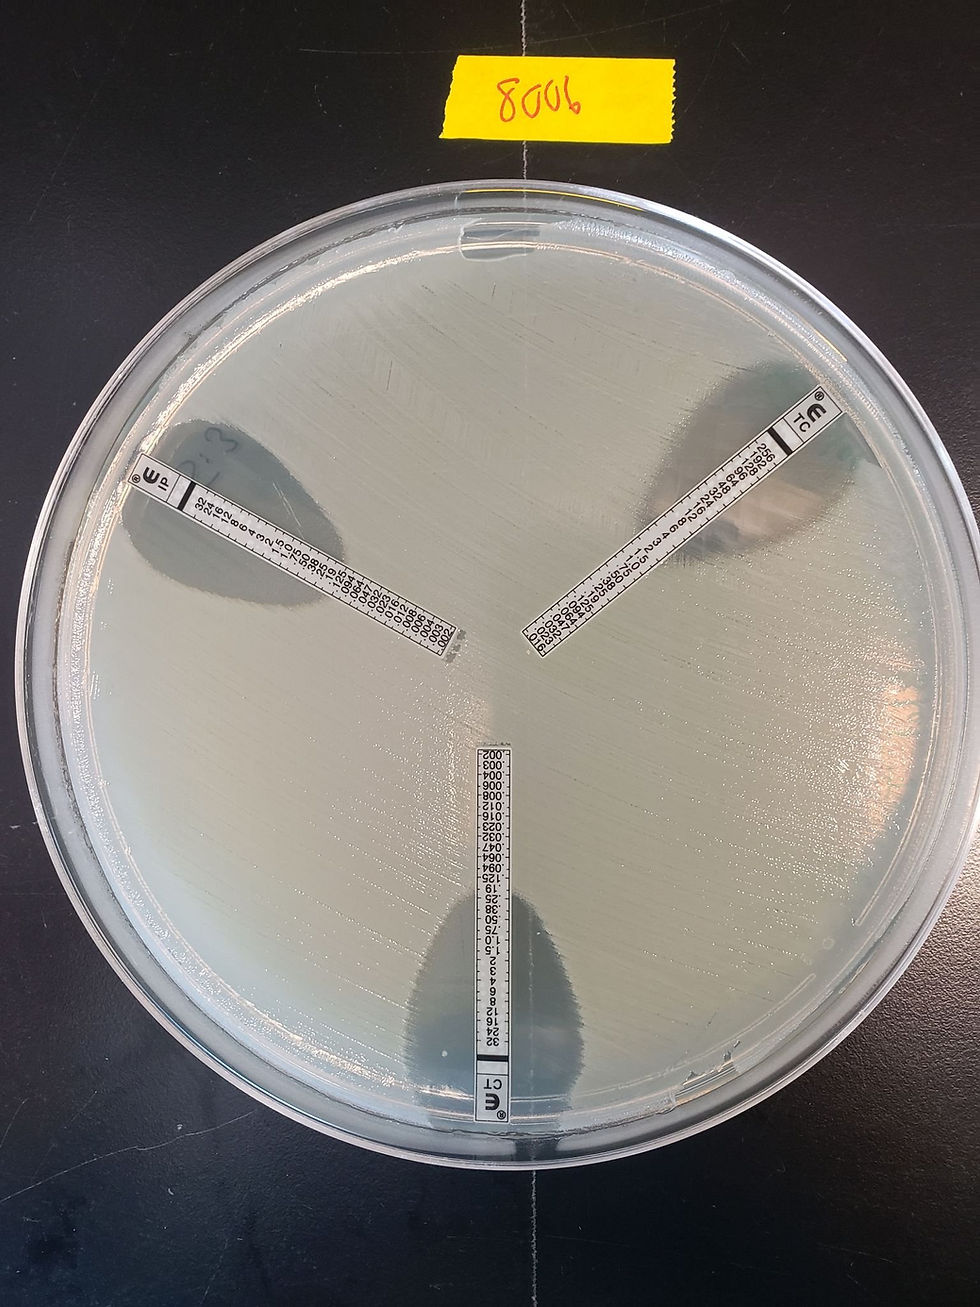
ree

Symposium on the NSERC Frontiers Project on antibiotic resistance in bioaerosols
- 1 nov. 2023
- 2 min de lecture
L’équipe de la professeure Caroline Duchaine vous invite au Symposium on the NSERC Frontiers Project on antibiotic resistance in bioaerosols qui se tiendra à l’auditorium Y2260 de l'Institut universitaire de cardiologie et de pneumologie de Québec-Université Laval les mercredi 1er et jeudi 2 novembre prochain. Professeure Duchaine est titulaire de la Chaire de recherche du Canada sur les bioaérosols et directrice de la recherche pour le projet Frontières de la découverte (2019) sur l’antibiorésistance dans les bioaérosols.
Cet évènement constitue une excellente opportunité de mieux connaître la diversité de nos expertises, de nos intérêts de recherche et ainsi d'ouvrir la voie à de nouvelles collaborations. Nous avons la chance d’y accueillir deux conférenciers de renom : Abia A. King et Simon Otto.
Dr. King est professeur associé honoraire de l'Université de KwaZulu Natal et chercheur à la Fondation pour la recherche environnementale en Afrique du Sud. Simon Otto lui, est vétérinaire, épidémiologiste et professeur adjoint à l'École de santé publique de l'Université de l'Alberta. Il dirige également le groupe de recherche HEAT-AMR (Human-Environment-Animal Transdisciplinary Antimicrobial Resistance).
Nous aurons l’occasion, lors de ce symposium, d’entendre également les étudiantes et étudiants présenter leurs projets de recherche lors de courtes conférences ainsi que lors de présentations par affiches.
PRÉSENTATIONS ORALES OU PAR AFFICHE:
La date limite pour soumettre votre résumé est le 15 octobre 2023 à 23h30. Les détails sont disponibles sous l’onglet "Instructions".
CONFÉRENCES ÉTUDIANTES/POSTDOC :
Cette année, plusieurs personnes étudiantes seront sélectionnées pour présenter oralement leur communication dans le cadre de conférences. Les personnes intéressées doivent soumettre leur résumé (onglet soumission) au plus tard le 15 octobre 2023 à 23h30 en spécifiant leur volonté de faire une présentation orale. Le comité scientifique fera une sélection à partir des résumés soumis et les personnes seront avisées avant le 25 octobre 2023.
En espérant vous y voir en grand nombre et bon symposium!
%20(1)%201.png)



Commentaires